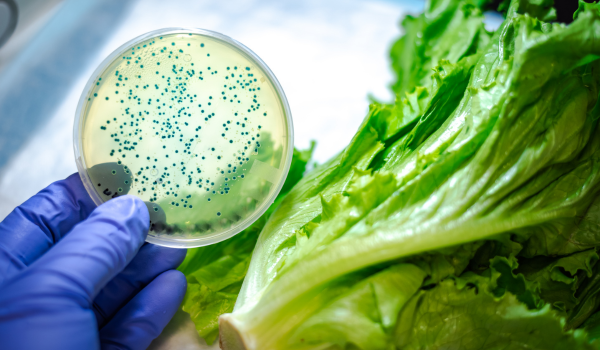
Hidden Dangers: Common Contaminants Behind Major Food Recalls

What Is a Food Recall?
A food recall happens when a company removes a food product from the market because it may cause health problems or violate safety standards. This can occur voluntarily—when a company detects an issue—or as a mandatory action by regulatory agencies like the U.S. Food and Drug Administration (FDA) or the U.S. Department of Agriculture (USDA).
The purpose of a recall is to protect consumers from potential harm. These actions may involve contamination, mislabeling, or undeclared allergens. When a recall occurs, affected products are removed from stores, restaurants, and sometimes even from consumers’ homes.
Food recalls are part of a broader food safety system that helps detect and prevent outbreaks before they escalate into public health crises. Understanding how they work allows you to make smarter and safer decisions about what you eat.
Why Do Food Recalls Happen?
Food recalls can occur for a variety of reasons, but they generally fall into four major categories:
-
Biological contamination – Usually caused by bacteria such as Salmonella, E. coli, or Listeria monocytogenes. These pathogens can trigger severe foodborne illnesses.
-
Chemical contamination – Occurs when cleaning agents, pesticides, or toxins are accidentally introduced into the food.
-
Physical contamination – Involves foreign materials like plastic, metal fragments, or glass pieces entering the product.
-
Labeling and allergen errors – When allergens such as peanuts, soy, or dairy are not properly disclosed on the label.
Other reasons may include packaging defects, improper storage, or temperature control issues throughout the supply chain.
The Three Classes of Food Recalls
Regulatory agencies classify food recalls based on severity:
-
Class I Recall: High risk — products that could cause serious health issues or death. Example: ready-to-eat meats contaminated with Listeria.
-
Class II Recall: Moderate risk — products that might cause temporary or reversible illness, such as mild allergic reactions.
-
Class III Recall: Low risk — labeling or manufacturing violations unlikely to cause health problems.
These classifications help authorities prioritize which recalls demand the fastest action.
How Do Food Recalls Work?
The recall process typically follows these steps:
-
Detection: A problem is identified through company testing, consumer complaints, or government inspection.
-
Notification: The company informs the FDA or USDA depending on product type.
-
Public announcement: A recall alert is issued via official websites, press releases, and media.
-
Product removal: Distributors and retailers remove affected items from circulation.
-
Verification: Authorities ensure all contaminated or mislabeled products are accounted for.
-
Resolution: The recall concludes once the company corrects the issue and confirms compliance.
Both the FDA and USDA maintain public recall databases so consumers can verify current alerts at any time.
What to Do If You Have a Recalled Product
If you discover that an item you purchased is part of a recall:
-
Stop using it immediately.
-
Follow official instructions — either return the item for a refund or safely dispose of it.
-
Do not donate or share recalled food products.
-
Clean all surfaces and containers that may have come into contact with it.
-
Monitor your health for potential symptoms of foodborne illness.
If you or someone in your family becomes ill, contact your doctor and report the issue to FDA MedWatch.
How Companies Manage Food Recalls
For businesses, a recall can be financially devastating and damaging to reputation. To minimize risk, most companies use traceability systems such as barcodes, RFID tags, and blockchain tracking.
They must act transparently with authorities and the public, following clear crisis management steps — identifying root causes, removing affected products, and preventing future incidents.
Recent Examples of Food Recalls
Some notable recalls in recent years include:
-
Peanut Butter Recall (2022): Salmonella contamination led to nationwide withdrawals.
-
Bagged Salad Recall: Multiple brands recalled due to Listeria contamination.
-
Frozen Berry Recall: Hepatitis A was detected through routine lab testing.
These incidents highlight that even everyday foods can pose hidden risks if safety controls fail.
How Food Recalls Protect Consumers
While recalls can be inconvenient, they serve an essential purpose: protecting lives. Their main benefits include:
-
Quick removal of hazardous products
-
Transparency between food companies and consumers
-
Higher quality control and stricter compliance standards
-
Greater consumer trust in food safety regulations
Without recalls, dangerous food products could remain on store shelves for weeks or months, causing severe outbreaks.
How Consumers Can Stay Prepared
You can minimize risk and act quickly during a food recall by:
-
Subscribing to recall alerts on FDA or USDA websites.
-
Staying updated through reliable news outlets.
-
Keeping product receipts or photos to verify lot numbers.
-
Practicing safe food handling: washing produce, cooking meats thoroughly, and avoiding cross-contamination.
-
Understanding expiration vs. safety labels: “best by,” “use by,” and “sell by” have different meanings.
Knowledge is the strongest defense against foodborne risk.
The Role of Technology in Preventing Recalls
Emerging technologies are revolutionizing food safety:
-
AI (Artificial Intelligence) detects abnormal patterns during production.
-
IoT sensors monitor temperature and storage conditions during transport.
-
Blockchain systems create transparent digital records across the supply chain.
These tools improve traceability and reduce recall scale when issues arise.
What Happens After a Recall Ends
Once a recall concludes, companies must conduct a root cause analysis to prevent similar problems. Common corrective actions include:
-
Revising supplier contracts
-
Improving sanitation protocols
-
Enhancing staff training
-
Installing real-time quality monitoring systems
Regulators often audit these changes before allowing normal production to resume.
The Global Impact of Food Recalls
Food recalls affect not just local markets but also global trade. Contaminated exports can trigger international restrictions or bans, harming economies and brand trust.
This is why organizations like the World Health Organization (WHO) and Codex Alimentarius Commission work to standardize international food safety practices.
Conclusion: Awareness Is the First Step to Safety
Food recalls are not signs of failure — they’re signs that the system works. By acting quickly, authorities and companies prevent mass illness and strengthen public trust.
Understanding how food recalls function empowers you to make safe, informed choices.
Every recall is a reminder that food safety is everyone’s responsibility — from producers to consumers.


.png)